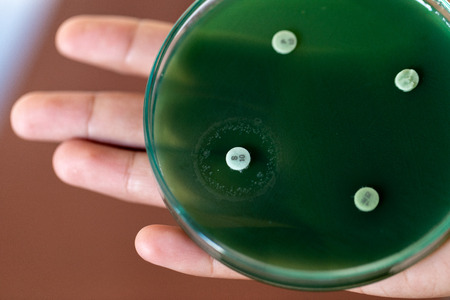
Drug testing of microbiology laboratory.の写真素材

写真素材 - Drug testing of microbiology laboratory.
キーワード
- agar
- antibiotic
- antimicrobial
- background
- bacteria
- bacterium
- biology
- biotechnology
- blood
- colonies
- colony
- culture
- disease
- dish
- drug
- equipment
- experiment
- gram
- growth
- hospital
- infection
- infectious
- isolated
- lab
- laboratory
- medical
- medicine
- microbiological
- microbiology
- organism
- penicillin
- petri
- pharmacy
- plate
- pneumoniae
- professional
- pseudomonas
- research
- safety
- sample
- science
- scientific
- scientist
- staphylococcus
- streptococcus
- study
- technology
- test
- tip
- virus
類似作品
Blurred of scie...
Researcher work...
Microbiology ha...
Researchers wor...
Research, exper...
Male doctor wor...
Working table w...
Streak plate fo...
Professional do...
Experienced lab...
chemist at blue...
Scientist in ha...
Pipette droppin...
Close-up of twe...
Research, exper...
Laboratory phar...
scientist worki...
Hands in blue g...
Scientists use ...
Bacterial cultu...
Vial of vaccine...
Hand holds a Pe...
white lab mouse...
Bacterial colon...
Petri dish with...
scientist worki...
blurry image of...
Cropped photo o...
Laboratorian in...
Flask and pipet...
Close up the me...
A drop at the e...
Petri dish with...
Scientist holdi...
Researcher hold...
Professional do...
Scientific Glas...
Analysis and st...
Close up of han...
Professional de...
Pharmaceutical ...
A hand in a rub...
some pearls wit...
E. coli growing...
Researchers wor...
chemist wearing...
Research, exper...
Hands of a scie...
Glass medical a...